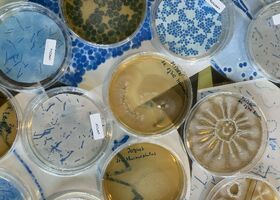

Otevírací doba
| Pondělí | Zavřeno |
|---|---|
| Úterý | 9:00–17:00 |
| Středa | 9:00–17:00 |
| Čtvrtek | 9:00–17:00 |
| Pátek | 9:00–17:00 |
| Sobota | 9:00–17:00 |
| Neděle | 9:00–17:00 |
Ve středu 22. dubna bude uzavřena expozice Gastronomie.
DOPRAVNÍ OMEZENÍ V OKOLÍ MUZEA OD 30. 3. DO 10. 5. 2026.
Z důvodu rekonstrukce vodovodu bude v tomto období omezen provoz v ulicích Muzejní, Letohradská, Ovenecká. Věnujte prosím pozornost dopravním omezením, pokud se chcete vyhnout komplikacím, využijte např. podzemní garáže na Letné. Ulice Ovenecká je neprůjezdná dlouhodobě. Děkujeme za pochopení.
Prodej vstupenek končí 30 minut před koncem otevírací doby muzea.
Parkování v okolí muzea je možné pouze na placených stáních (parkovací automat nebo aplikace easy park, pid lítačka atd.), případně v podzemních garážích na Letné. Při větších akcích doporučujeme využít dopravu MHD.
Návštěvníci muzea mohou během procházek expozicemi zavítat také do Mlsné kavárny nebo využít samoobslužnou kavárnu Koala Coffee. Mlsná kavárna je otevřena i pro veřejnost, která nejde do muzea, stejně jako pro návštěvníky muzejního dvora.
Těšíme se na vaši návštěvu!
Vstupné
| dospělí | 250 Kč |
|---|---|
| děti a mládež do 18 let, středoškoláci nad 18 let v rámci školních skupin Vstup pro děti a mládež zdarma platí do všech expozic a výstav muzea. Neplatí na akce pořádané NZM. | Zdarma |
| studenti 18–26 let | 100 Kč |
| senioři od 65 let | 100 Kč |
| permanentka 6 jednorázových vstupů platnost 365 dní od zakoupení, přenosná, jednorázový vstup pro jednoho platícího návštěvníka v jednom dni | 1000 Kč |
| permanentka 12 jednorázových vstupů platnost 365 dní od zakoupení, přenosná, jednorázový vstup pro jednoho platícího návštěvníka v jednom dni | 1800 Kč |
| zájmové skupiny nad 10 osob starších 18 let (cena za osobu) cena za osobu | 100 Kč |
* Vstup pro děti a mládež zdarma platí do všech expozic a výstav muzea. Neplatí na akce pořádané NZM.
* Benefitní karty nepřijímáme. NZM je mylně uvedeno v seznamu mujup.cz, řešíme s provozovatelem.